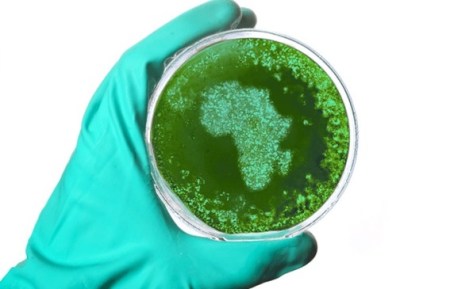

With limited laboratory capacity and a lack of experts and funding, an outbreak of the Zika virus in Africa could be problematic.
Sourced through Scoop.it from: theconversation.com
Yeah…sure. It could be Bad.
BUT: as South African epidemiologists have pointed out, it’ll only be a problem IF the mosquito that transmits it elsewhere, comes here – because our local A aegypti doesn’t have the same behaviour, and will vastly outnumber and possibly outcompete any import variety.
And it’s endemic in tropical Africa – meaning many people are immune already.
So scaremongering about Zika in Africa is possibly a little irresponsible – unless it’s being used as a stalking horse for an agenda for setting up continent-wide arbovirus surveillance, or spurring on efforts to set up an African CDC. Which I would heartily endorse.
The stuff about lack of reagents is spot-on: which is why we have a proposal in the works to provide just such, using plants to it. Watch this space….
See on Scoop.it – Virology News
10 February, 2016 at 09:55 |
Reblogged this on Michelo Simuyandi and commented:
Well said
LikeLike